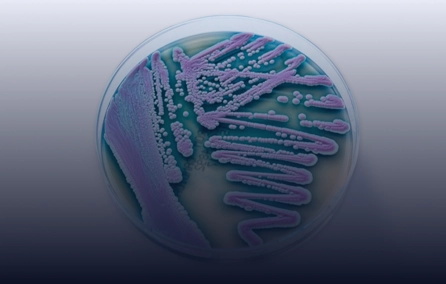
Relevância e implicações fisiopatológicas da sensibilização fúngica na asma e seus sub-endótipos

Alergia
Alergias são respostas exageradas resultantes da hipersensibilidade do sistema imunitário a uma determinada substância (alérgeno). Os alérgenos podem causar alergias ao serem inalados, ingeridos, tocados ou injetados, provocando sintomas caraterísticos. As alergias são um tema de estudo importante e diversificado no iii-INCT. Fazemos estudos de alergias a medicamentos, a venenos de insetos, a alimentos e em vários tipos de alergias respiratórias. Uma linha de pesquisa mais recente aborda distúrbios do sono e do ciclo circadiano nesses pacientes.